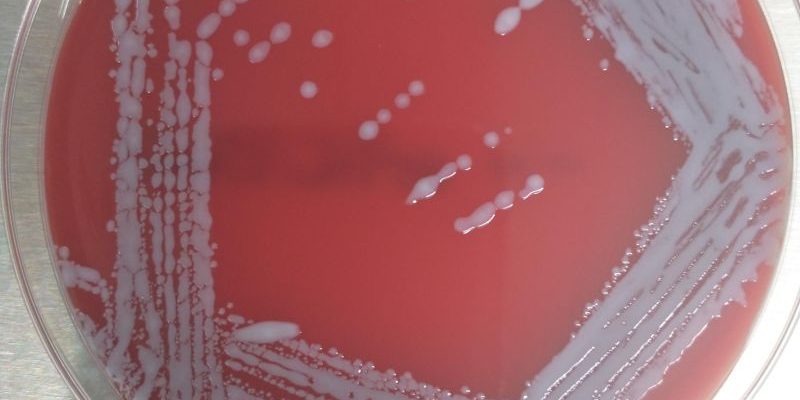
1668678023617

La epidermitis exudativa es una enfermedad cutánea de origen bacteriano que puede aparecer a cualquier edad y que acaba afectando a la mayoría de granjas.
La bacteria responsable es la Staphylococcus hyicus y genera una secreción sebácea de la piel, además de la formación de una capa de corteza, que puede llegar a cubrir todo el cuerpo del animal.
Esta semana ha llegado un caso a Zenit, en el que hemos podido observar que el animal objeto de análisis presentaba exfoliación severa de la piel con zonas totalmente ulceradas. Este grado de lesión supone la pérdida completa de protección cutánea contra cualquier agente infeccioso oportunista.
El diagnóstico del caso fue corroborado por aislamiento bacteriano gracias al cultivo que realizamos en nuestro laboratorio, pero uno de los aspectos más destacables del S. hyicus es su capacidad de desarrollar resistencias a los antibióticos. Por este motivo, desde Zenit hemos iniciado el proceso de autovacuna con nuestros partners AniCon Labor GmbH, para así conseguir un control rápido de la enfermedad y su curación clínica.
Desde Zenit vamos más allá del diagnóstico para ofrecer un servicio más completo y una mayor información.